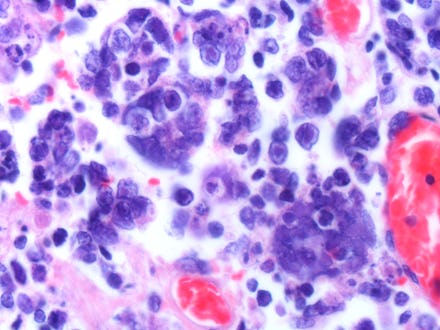

Scientists Have Figured Out How to Use the Herpes Virus to Fight Skin Cancer
On Tuesday, the Food and Drug Administration approved a drug that uses the herpes simplex virus to sneak into — and annihilate — skin cancer cells.
Studies conducted by manufacturer Amgen Inc. show the drug, Imlygic, shrunk melanomas in about "about 16% of patients injected with the drug ... compared with 2% of patients who took more conventional cancer drugs," CBS News reports. It has no effect on skin cancer that has spread to other regions of the body.
Amgen Inc. told CBS News one course with the drug would cost approximately $65,000.
Imlygic piggybacks into skin-cancer cells using a modified herpes virus and then replicates rapidly, destroying the cells from within, at the same time triggering the body's immune system into a heightened response against skin tumors.
In an announcement on its website, the FDA hailed Imlygic as the "first FDA-approved oncolytic virus therapy" and noted 74,000 Americans are diagnosed with and 10,000 Americans die from melanoma annually.
"Melanoma is a serious disease that can advance and spread to other parts of the body, where it becomes difficult to treat," Research Dr. Karen Midthun, director of the FDA's Center for Biologics and Research, wrote in the statement. "This approval provides patients and health care providers with a novel treatment for melanoma."
However, side effects noted by the FDA included "fatigue, chills, fever, nausea, flu-like symptoms and pain at the injection site" as well as possible herpes virus infection.
According to the Skin Cancer Foundation, "more people have had skin cancer than all other cancers combined" over the past three decades, and it is the only one of the seven most common types of cancer that is becoming more common. The foundation notes approximately 40 to 50% of people who live to age 65 or older will experience the non-melanoma skin cancers of either basal cell carcinoma or squamous cell carcinoma "at least once."